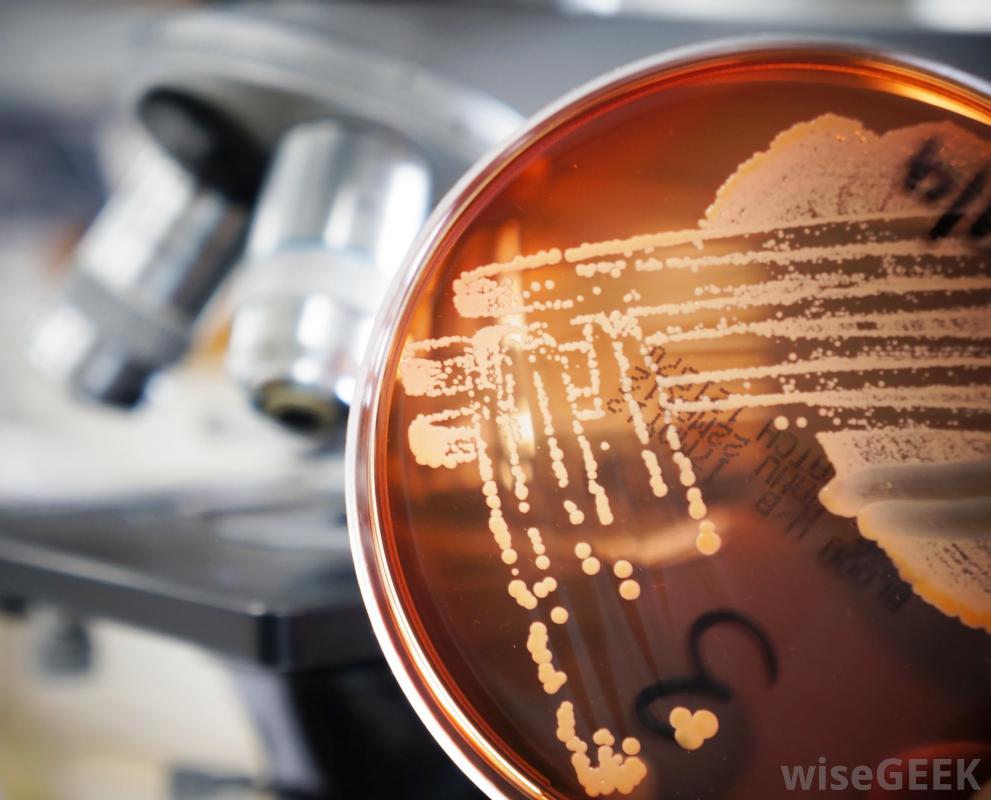

發中發
發中發是大型的國際娛樂游戲的NO.1,足球籃球投注等多款游戲,官方穩定返現高,最高返現888,玩家可以在網頁上登錄注冊,官網還提供app下載。抗生素對膿毒癥有多有效(Effective are Antibiotics for Sepsis)?_www.xcic.net
抗生素對膿毒癥的有效性取決于許多因素。治療最成功的是健康患者,他們接受了及時的重癥護理,并且沒有發生敗血癥性休克。炎癥和隨后的缺氧是膿毒癥期間器官損害的主要原因,這些都會對抗生素治療的成功產生不利影響。如果感染是由抗藥性細菌引起的,并發癥就更容易發生。新生兒敗血癥尤其危險,需要在抗菌素和其他治療手段之間保持微妙的平衡,以防死亡或腦損傷 抗生素治療鼻中隔的療效最好,全身性細菌感染可導致敗血癥使免疫系統產生炎癥反應。醫院對其進行治療,包括液體支持劑、抗菌劑和消炎劑。抗生素是治療的基礎,因為對抗細菌的傳播及其毒素的影響對患者的生存至關重要膿毒癥取決于所涉及的特定微生物和患者免疫系統的強度等因素。如果許多組織發炎,血液凝固會切斷氧氣供應并導致多個器官衰竭,這種情況稱為敗血癥性休克
抗生素治療鼻中隔的療效最好,全身性細菌感染可導致敗血癥使免疫系統產生炎癥反應。醫院對其進行治療,包括液體支持劑、抗菌劑和消炎劑。抗生素是治療的基礎,因為對抗細菌的傳播及其毒素的影響對患者的生存至關重要膿毒癥取決于所涉及的特定微生物和患者免疫系統的強度等因素。如果許多組織發炎,血液凝固會切斷氧氣供應并導致多個器官衰竭,這種情況稱為敗血癥性休克 呼吸困難和心率減慢是新生兒敗血癥的癥狀,當患者在感染期間迅速用藥,而尚未使用抗生素時,抗生素對敗血癥的療效最高感染性休克引起的持續性低血壓。早期治療降低了患者因免疫反應而休克的幾率,從而降低了器官損傷的風險,并使抗生素有足夠的時間來破壞或降低細菌血球計數。醫院危重病護理的總體質量是對于減少細菌分泌的炎癥或毒素的影響和影響治療的有效性非常重要。心臟瓣膜手術的患者如果感染了膿毒癥,則有很高的并發癥風險。
呼吸困難和心率減慢是新生兒敗血癥的癥狀,當患者在感染期間迅速用藥,而尚未使用抗生素時,抗生素對敗血癥的療效最高感染性休克引起的持續性低血壓。早期治療降低了患者因免疫反應而休克的幾率,從而降低了器官損傷的風險,并使抗生素有足夠的時間來破壞或降低細菌血球計數。醫院危重病護理的總體質量是對于減少細菌分泌的炎癥或毒素的影響和影響治療的有效性非常重要。心臟瓣膜手術的患者如果感染了膿毒癥,則有很高的并發癥風險。 一盤催產克雷伯菌,這可能導致敗血癥。醫院獲得性感染是由細菌引起的,這些細菌已經對許多正常處方的抗生素產生了抗藥性。即使是早期和適當的藥物選擇,耐藥菌引起的敗血癥有較高的死亡率,例如金黃色葡萄球菌對青霉素和類似藥物具有耐藥性,有時頭孢菌素類抗生素在醫院獲得性敗血癥的治療中相當成功,但有些微生物甚至對這些藥物產生了抗藥性氨基糖苷類藥物可有效減少耐藥菌引起的患者死亡,但這些藥物有時會導致腎臟損害。新生兒敗血癥的抗生素治療相當具有挑戰性。新生兒敗血癥有死亡率在未經治療的病例中,感染率高達50%,有時是由于細菌性腦膜炎引起的腦部炎癥。如果新生兒敗血癥早期發生,靜脈注射抗生素是相當有效的。治療這類敗血癥的抗生素的選擇因細菌類型、母親的病史而不同,以及嬰兒接受治療的特定重癥監護病房的感染率。
一盤催產克雷伯菌,這可能導致敗血癥。醫院獲得性感染是由細菌引起的,這些細菌已經對許多正常處方的抗生素產生了抗藥性。即使是早期和適當的藥物選擇,耐藥菌引起的敗血癥有較高的死亡率,例如金黃色葡萄球菌對青霉素和類似藥物具有耐藥性,有時頭孢菌素類抗生素在醫院獲得性敗血癥的治療中相當成功,但有些微生物甚至對這些藥物產生了抗藥性氨基糖苷類藥物可有效減少耐藥菌引起的患者死亡,但這些藥物有時會導致腎臟損害。新生兒敗血癥的抗生素治療相當具有挑戰性。新生兒敗血癥有死亡率在未經治療的病例中,感染率高達50%,有時是由于細菌性腦膜炎引起的腦部炎癥。如果新生兒敗血癥早期發生,靜脈注射抗生素是相當有效的。治療這類敗血癥的抗生素的選擇因細菌類型、母親的病史而不同,以及嬰兒接受治療的特定重癥監護病房的感染率。 處方抗生素。
處方抗生素。
 抗生素治療鼻中隔的療效最好,全身性細菌感染可導致敗血癥使免疫系統產生炎癥反應。醫院對其進行治療,包括液體支持劑、抗菌劑和消炎劑。抗生素是治療的基礎,因為對抗細菌的傳播及其毒素的影響對患者的生存至關重要膿毒癥取決于所涉及的特定微生物和患者免疫系統的強度等因素。如果許多組織發炎,血液凝固會切斷氧氣供應并導致多個器官衰竭,這種情況稱為敗血癥性休克
抗生素治療鼻中隔的療效最好,全身性細菌感染可導致敗血癥使免疫系統產生炎癥反應。醫院對其進行治療,包括液體支持劑、抗菌劑和消炎劑。抗生素是治療的基礎,因為對抗細菌的傳播及其毒素的影響對患者的生存至關重要膿毒癥取決于所涉及的特定微生物和患者免疫系統的強度等因素。如果許多組織發炎,血液凝固會切斷氧氣供應并導致多個器官衰竭,這種情況稱為敗血癥性休克 呼吸困難和心率減慢是新生兒敗血癥的癥狀,當患者在感染期間迅速用藥,而尚未使用抗生素時,抗生素對敗血癥的療效最高感染性休克引起的持續性低血壓。早期治療降低了患者因免疫反應而休克的幾率,從而降低了器官損傷的風險,并使抗生素有足夠的時間來破壞或降低細菌血球計數。醫院危重病護理的總體質量是對于減少細菌分泌的炎癥或毒素的影響和影響治療的有效性非常重要。心臟瓣膜手術的患者如果感染了膿毒癥,則有很高的并發癥風險。
呼吸困難和心率減慢是新生兒敗血癥的癥狀,當患者在感染期間迅速用藥,而尚未使用抗生素時,抗生素對敗血癥的療效最高感染性休克引起的持續性低血壓。早期治療降低了患者因免疫反應而休克的幾率,從而降低了器官損傷的風險,并使抗生素有足夠的時間來破壞或降低細菌血球計數。醫院危重病護理的總體質量是對于減少細菌分泌的炎癥或毒素的影響和影響治療的有效性非常重要。心臟瓣膜手術的患者如果感染了膿毒癥,則有很高的并發癥風險。 一盤催產克雷伯菌,這可能導致敗血癥。醫院獲得性感染是由細菌引起的,這些細菌已經對許多正常處方的抗生素產生了抗藥性。即使是早期和適當的藥物選擇,耐藥菌引起的敗血癥有較高的死亡率,例如金黃色葡萄球菌對青霉素和類似藥物具有耐藥性,有時頭孢菌素類抗生素在醫院獲得性敗血癥的治療中相當成功,但有些微生物甚至對這些藥物產生了抗藥性氨基糖苷類藥物可有效減少耐藥菌引起的患者死亡,但這些藥物有時會導致腎臟損害。新生兒敗血癥的抗生素治療相當具有挑戰性。新生兒敗血癥有死亡率在未經治療的病例中,感染率高達50%,有時是由于細菌性腦膜炎引起的腦部炎癥。如果新生兒敗血癥早期發生,靜脈注射抗生素是相當有效的。治療這類敗血癥的抗生素的選擇因細菌類型、母親的病史而不同,以及嬰兒接受治療的特定重癥監護病房的感染率。
一盤催產克雷伯菌,這可能導致敗血癥。醫院獲得性感染是由細菌引起的,這些細菌已經對許多正常處方的抗生素產生了抗藥性。即使是早期和適當的藥物選擇,耐藥菌引起的敗血癥有較高的死亡率,例如金黃色葡萄球菌對青霉素和類似藥物具有耐藥性,有時頭孢菌素類抗生素在醫院獲得性敗血癥的治療中相當成功,但有些微生物甚至對這些藥物產生了抗藥性氨基糖苷類藥物可有效減少耐藥菌引起的患者死亡,但這些藥物有時會導致腎臟損害。新生兒敗血癥的抗生素治療相當具有挑戰性。新生兒敗血癥有死亡率在未經治療的病例中,感染率高達50%,有時是由于細菌性腦膜炎引起的腦部炎癥。如果新生兒敗血癥早期發生,靜脈注射抗生素是相當有效的。治療這類敗血癥的抗生素的選擇因細菌類型、母親的病史而不同,以及嬰兒接受治療的特定重癥監護病房的感染率。 處方抗生素。
處方抗生素。
- 發表于 2020-08-10 23:03
- 閱讀 ( 1105 )
- 分類:醫療衛生
你可能感興趣的文章
- 囊性纖維化和假單胞菌之間有什么聯系(the Connection between Cystic Fibrosis and Pseudomonas)? 1383 瀏覽
- β受體阻滯劑過量的跡象是什么(Signs of a Beta Blocker Overdose)? 1529 瀏覽
- 什么是虹膜學(Iridology)? 1016 瀏覽
- 輪盤賭算法 791 瀏覽
- 什么是Tanorexia(Tanorexia)? 604 瀏覽
- 什么是心臟手術(Cardiac Surgery)? 693 瀏覽
- 遺尿癥和遺尿癥有什么區別(the Difference between Encopresis and Enuresis)? 649 瀏覽
- 如何選擇治療拔毛癥的最佳方法(Choose the Best Treatment for Trichotillomania)? 563 瀏覽
- 什么是滴蟲學(Trichology)? 712 瀏覽
- 有哪些不同類型的內窺鏡檢查鎮靜劑(Different Types of Endoscopy Sedation)? 781 瀏覽
- 奎硫平是什么(Quetiapine)? 1390 瀏覽
- 什么是便攜式霧化器(Portable Nebulizer)? 1128 瀏覽
- 什么是少汗性外胚層發育不良(Hypohidrotic Ectodermal Dysplasia)? 1050 瀏覽
- 什么是鑄造臺(Casting Stand)? 782 瀏覽
- 什么是腳疝(Crural Hernia)? 1279 瀏覽
- 什么是心理咨詢(Counseling Psychology)? 997 瀏覽
- 什么是心肌炎(Myocarditis)? 681 瀏覽
- 什么是草藥含片(Herbal Lozenges)? 706 瀏覽
- 什么是便盆洗衣機(Bedpan Washer)? 863 瀏覽
- 他達拉非是什么(Tadalafil)? 910 瀏覽
- 什么是視覺優勢(Ocular Dominance)? 2257 瀏覽
- 如何治療股四頭肌拉傷(Treat a Pulled Quadricep)? 761 瀏覽
- ERCP的潛在并發癥是什么(Potential Complications of ERCP)? 707 瀏覽
- 什么是肌電圖(Myogram)? 865 瀏覽
- 什么是CRP(CRP)? 994 瀏覽
- 起搏器最常見的并發癥是什么(Most Common Pacemaker Complications)? 710 瀏覽
- 萬成娛樂 688 瀏覽
- 接觸性皮炎有哪些不同的治療方法(Different Contact Dermatitis Treatments)? 1076 瀏覽
- 老撾賭博官網 667 瀏覽
- 嗎啡成癮的癥狀是什么(Signs of Morphine Addiction)? 772 瀏覽
相關問題
0 條評論
請先 登錄 后評論
admin
0 篇文章
作家榜 ?
-
 xiaonan123
189 文章
xiaonan123
189 文章
-
 湯依妹兒
97 文章
湯依妹兒
97 文章
-
 luogf229
46 文章
luogf229
46 文章
-
 jy02406749
45 文章
jy02406749
45 文章
-
 小凡
34 文章
小凡
34 文章
-
 Daisy萌
32 文章
Daisy萌
32 文章
-
 我的QQ3117863681
24 文章
我的QQ3117863681
24 文章
-
 華志健
23 文章
華志健
23 文章
推薦文章
- 什么是堿性潮(the Alkaline Tide)?
- 如何選擇最好的鼻腔沖洗系統(Choose the Best Nasal Irrigation System)?
- 維生素D過量的癥狀是什么(Symptoms of a Vitamin D Overdose)?
- 利福昔明對肝性腦病的療效如何(Effective Is Rifaximin for Hepatic Encephalopathy)?
- 什么是冠狀動脈痙攣(Coronary Artery Spasm)?
- 博萊霉素對疣有多有效(Effective Is Bleomycin for Warts)?
- 什么是運動障礙(Dyskinesias)?
- 豪森娛樂
- 什么是雙側髕骨(Bipartite Patella)?
- 什么是煙酸解毒藥(Niacin Detox)?
- 什么是鼻竇息肉(Sinus Polyps)?
- 澳門博彩立博
- 現場21點
- 草藥中常用的植物有哪些(Commonly Used Plants in Herbal Medicine)?
- 什么是假勞動(False Labor)?
- 百老匯娛樂
- 什么是思想停止(Thought Stopping)?
- 如何選擇最好的天然抗酸劑(Choose the Best Natural Antacid)?
- 什么是季節性過敏(Seasonal Allergies)?
- 抗生素霜對痤瘡有多有效(Effective Is Antibiotic Cream for Acne)?
- 什么是合成代謝(Anabolism)?
- 什么是民進黨4(DPP 4)?
- 什么是指甲真菌(Fingernail Fungus)?
- 什么是組胺受體拮抗劑(Histamine Receptor Antagonist)?
- 什么是流行性斑疹傷寒(Epidemic Typhus)?
- 楔形枕頭對胃酸反流有多有效(Effective is a Wedge Pillow for Acid Reflux)?
- 什么是胚胎學(Embryology)?
- 什么是肌腱切開術(Tenotomy)?
- 格雷的解剖學是什么(Gray's Anatomy)?
- 癡呆癥藥物有哪些不同類型(Different Types of Dementia Medication)?